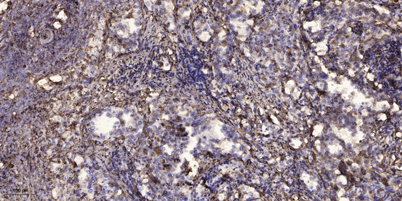

$148.00/50µL $248.00/100µL
| 50 µL | $148.00 |
| 100 µL | $248.00 |
| Product name: | SNM1B rabbit pAb |
| Reactivity: | Human;Rat;Mouse; |
| Alternative Names: | DCLRE1B; SNM1B; 5' exonuclease Apollo; DNA cross-link repair 1B protein; SNM1 homolog B; SNMIB; hSNM1B |
| Source: | Rabbit |
| Dilutions: | WB 1:500-2000;IHC-p 1:50-300; ELISA 2000-20000 |
| Immunogen: | Synthesized peptide derived from the C-terminal region of human SNM1B. |
| Storage: | -20°C/1 year |
| Clonality: | Polyclonal |
| Isotype: | IgG |
| Concentration: | 1 mg/ml |
| Observed Band: | 60kD |
| GeneID: | 64858 |
| Human Swiss-Prot No: | Q9H816 |
| Cellular localization: | Chromosome, telomere. Nucleus. Cytoplasm, cytoskeleton, microtubule organizing center, centrosome. Mainly localizes to telomeres, recruited via its interaction with TERF2. During mitosis, localizes to the centrosome. |
| Background: | DNA interstrand cross-links prevent strand separation, thereby physically blocking transcription, replication, and segregation of DNA. DCLRE1B is one of several evolutionarily conserved genes involved in repair of interstrand cross-links (Dronkert et al., 2000 [PubMed 10848582]).[supplied by OMIM, Mar 2008], |